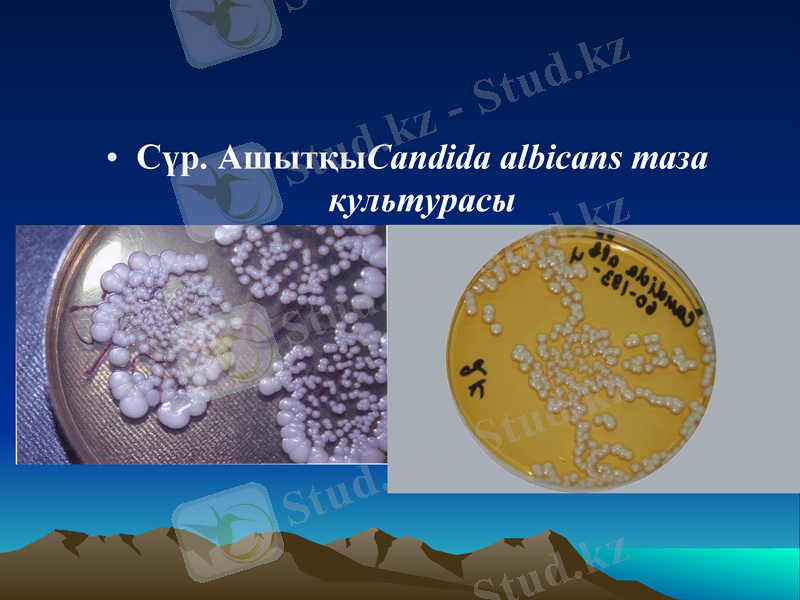
Slide 6
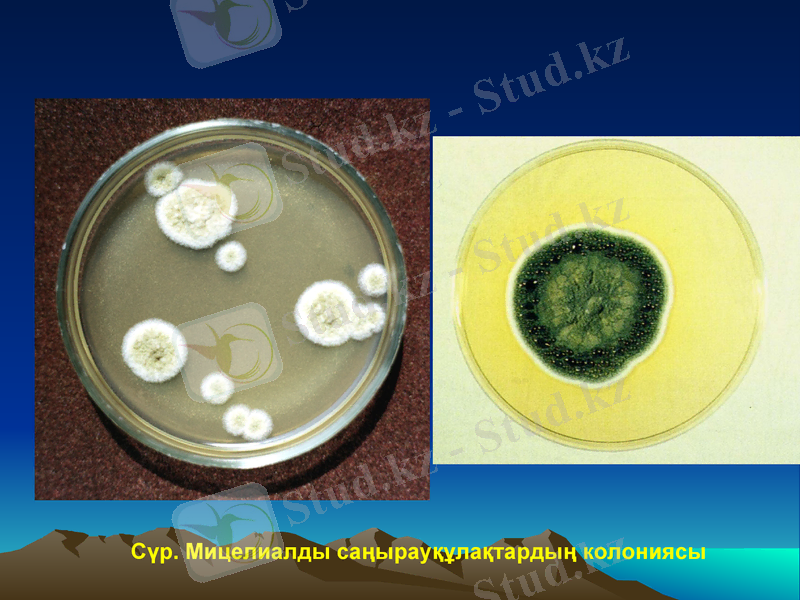
Slide 7
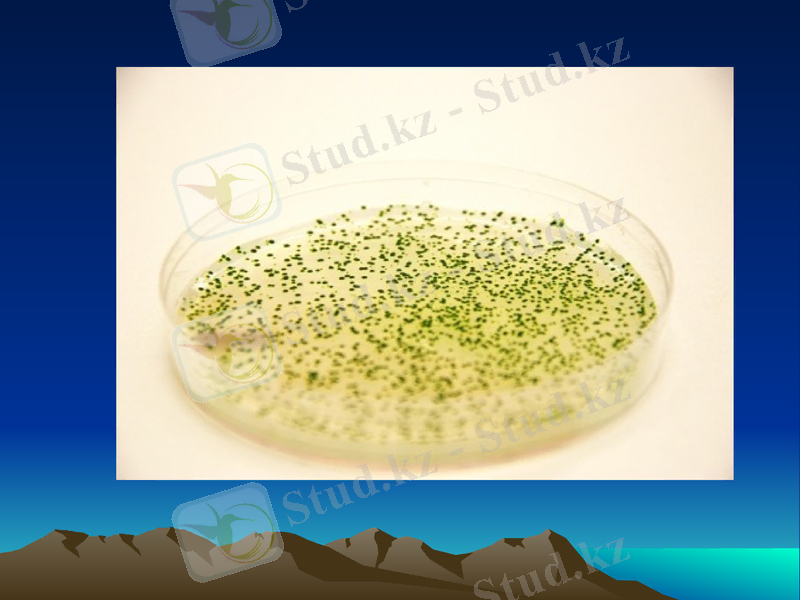
Slide 8

Микроорганизмдерді культивтеу әдістері мен өсу заңдылықтары



П Р Е З Е Н Т А Ц И Я ТАҚЫРЫБЫ: Культивирлеу және микроорганизмдердің өсуі ОРЫНДАҒАН: АЙТЕН А. ХТ 18-5К4 ҚАБЫЛДАҒАН:РЫСБАЕВА Г.

Жоспары
1. Микроорганизмдердің таза және жинақтаушы культурасы туралы ұғым
2. Беттік культиверлеу
3. Түптік культиверлеу
4. Статикалық және үздіксіз культуралардың өсу заңдылықтары
5. Микрорганизмнің өсу фазалары
6. Бақылау сұрақтар

Коректік ортада микроорганизмдердің өсуі культивирлеу деп аталады. Культуралардың өсуі кезінде физиологиялық процесс жүреді, нәтижесінде биомасса ұлғаяды. Биомасса- осы микроорганизмнің клеткалық затының массасы.
Микроорганизмдердің культивирлеу туралы ұғым

Микроорганизмнің таза культурасы
Микроорганизмнің таза культурасы бір ұрпақты клетка деп аталады. Таза культураны табиғи жолмен алу мүмкін емес, сондықтан оны жасанды жолмен алады. Таза дақылдың бөлінуi үшiн әр жасушаға бөлек колония түрде өскен тығыз қоректiк орталар, бiр түрдегі микроорганизмдердің популяцияларын пайдаланады.
Азық-түлік өнімдері немесе табиғи субстраттан (топырақ, су және т. б) микроорганизмдердің таза культурасын бөліп алу үшін, алдымен жинақтаушы культураны алады, яғни элективті қоректік орталарда өсіреді.

Элективті қоректік орта, NaCl қосылған: Staphylococcus aureus культивирлеу үшін пайдаланады. Колониялар сары түсті болып оседі.
Сүр. АшытқыCandida albicans таза культурасы
Сүр. Мицелиалды cаңырауқұлақтардың колониясы

Жинақтаушы культура
Жинақтаушы культура көбінесе бір түрге жататын микроорганизм клеткаларынан тұрады. Элективті (жинақтаушы) жағдайлар - бір ғана культураның дамуына жағдай жасап, басқа микроорганизмдердің өсуін тежейтін жағдайлар. Жинақтаушы орталарды пайдаланып жинақтаушы жағдайды қалыптастыруға болады. Мысалы элективті жағдайларға:жоғары температура, қышқылдың жоғарлануы, тұздың концентрациясының жоғарлануы т. б. жатады.

Әдетте таза культураны сақтау тығыз қоректік ортада, пробиркаларда жүргізіледі. Мұндай кезде жаңа қоректік ортаға жиі көшіріп отыру керек.
Таза дақылдарды сақтаудың басқа тәсiлдерiне: оларды жинақтаушы ортада, вазелин майының қабатының астында және лиофилизацияланған күйде сақтау жатады
( тоңазытылған микроорганизм клеткаларын вакууммен кептіру) .
Таза культураны сақтау тәсілдері :

Өнеркәсіптік микрорганизмдердің таза дақылдарын алу
Тамақ өнеркәсiбiнде өндiрiс үшiн бағалы қасиетке ие: ашытқыларды, сiрке қышқылды және пропионқышқылы бактериялардың таза культураларын қолданады. Соңғы кезде, екі немесе одан көп микрорганизмдердің түрлерінен тұратын көп компонентті таза культуралар қолданыс тапқан.
Ғылыми зертханаларда өнеркәсіптік микрорганизмдердің таза дақылдарын алу жұмыстары жүзеге асырылады. Мұнда оларды әр түрлi субстраттардан бөліп алып, зерттейдi, және өндiрiс үшiн ең өнiмдi, жарамды, таза дақылдарды мұражайдың топтамасында сақтайды. Микробиологиялық зауыт зертханада өндiрiстiк цикл үшiн культуралар дайындалады, оның биологиялық тазалығы, белсендiлiгі тексерiледі.

Микроорганизмдердің культиверлеу тәсілдері.
Культиверлеу тәсілі культиверлеудің түпкі мақсатына байланысты (мақсаты ретінде биомасса жинау немесе белгілі бір тіршілік әрекеті өнімін - метаболитті өндіру болып табылады) .
Микроорганизмдердің культиверлеу тәсілдерінің келесі түрлерін ажыратады:
Беттік культиверлеу
Түптік культиверлеу
Мерзімді культиверлеу.
Үздіксіз культиверлеу

Беттік культиверлеу деп аэробты микроарганизмдерді сұйық және сусымалы орталардың бетінде өсіруді айтамыз. Бұл ретте микроорганизмдер оттегіні тікелей ауадан алады. Беттік культиверлеулеу кезінде микроорганизмдер сұйық орталардың бетінде қабыршақ түрінде өседі. Беттік культиверлеу арнайы ванналарда - кюветаларда орындалады. Әдістің кемшілігі үлкен аймақты қажет ететіндігі. Беттік культивирлеудің басты артықшылығы - ақырғы өнім концентрациясының жоғары болуы. Беттік культураларды кептіру процесі оңай әрі тез жүреді. Оларды тауарлық күйге көшіру оңай және тасымалдауға ыңғайлы. Түптік әдіспен салыстырғанда энергия шығыны үлкен емес.
Беттік культиверлеу

Түптік культиверлеу - микроорганизмдер қоректік ортаның барлық көлемінде дами алатын сұйық қоректік орталарда жүргізіледі. Қоректік орта мен ондағы өсетін микроорганизмдердің үйлесімі культуралды сұйықтық деп аталады. Түптік культиверлеу арнайы аппараттарда -арнайы араластырғыштармен және аэробты микроорганизмдердің өсуін қамтамасыз ету үшін, таза ауа жеткізу жүйесімен жабдықталған, ферментаторларда жүзеге асырылады. Аэрация деп культуралды сұйықтық арқылы таза ауаны үрлеуді айтамыз. Барлық процесс қатаң асептикалық жағдайда жүргізілуі керек.
Түптік культиверлеу:

Түптік культиверлеу
Ферментаторлар
Арнайы араластырғыштар

Мерзімді культиверлеу кезінде қоректік ортының барлық көлемін таза культурамен егіп тастайды, ол қолайлы жағдайларда, белгілі уақыт аралығында, мақсатты өнімнің керекті мөлшерін жинағанша өсіріледі. Культиверлеу жаңартылмайтын қоректік ортада (стационарлық ортада) жүргізілетіндіктен, клеткалар үнемі өзгермелі жағдайда болатынын атап кеткен жөн. Сөйтіп периодтық жүйені тұйық жүйе ретінде қарастыруға болады.
Беттік культиверлеу тек қана мерзімді(периодты) бола алады, ал түптік культиверлеуді мерзімді де, үздіксіз де әдістерімен жүзеге асыруға болады.
Мерзімді культиверлеу:

Үздіксіз культиверлеу кезінде культура арнайы аппаратта орналасады, ол жерге үздіксіз қоректік орта келіп түседі және сол жерден сондай жылдамдықпен культуралдық сұйықтық сыртқа шығарылып отырады. Микроорганизм үшін өзгермейтін орта жағдайлары жасалады, сондықтан үздіксіз жүйені ашық жүйе ретінде қарастыруға болады.
Үздіксіз культиверлеу:

Статикалық және үздіксіз культуралардың өсу заңдылықтары
Культиверлеудің мерзімді әдісі кезінде микроорганизмдер популяциясы өсудің 7 сатысынан (фазаларынан) өтеді:
1. Лагфаза
2. Өсудің үдеу фазасы.
3. Экспоненциалды (логарифмді) өсу фазасы.
4. Өсудің бәсеңдеу фазасы.
5. Стационарлық фаза.
6. Өлудің үдеу фазасы.
7. Өлу фазасы.

Бактериялардың көбеюі
Көбеюдің тежелу фазасы. Мұны лагфаза деп те атайды. Бұл фазада бактериялардың көбеюі байқалмайды олар мұнда жаңа қоректік ортаға бейімделіп жатады. Бұл фаза 1 - 2 сағатқа созылады Фазаның аяқ шенінде клеткалар көбейе бастайды. Қоректік ортаға олардың әсері күшейе түседі.
I

Генерация мерзімі
-15-17 мин
- 23 - мин

Үздіксіз культиверлеу кезінде культура белгілі бір өсу фазасында тұрақталады.
Егер культиверлеудің мақсаты продуценттің биомассасын алу болса, процессті логарифмдік фазасы тәртібінде өткізген жөн. Бұл кезде микроорганизм популяция өсуінің максималды жылдамдығын қамтамасыз ете алады.
Культураны логарифмдік фазада сақтау үшін микробты популяцияны культиверлеу хемостат немесе турбиостатта жүргізіледі.

- Іс жүргізу
- Автоматтандыру, Техника
- Алғашқы әскери дайындық
- Астрономия
- Ауыл шаруашылығы
- Банк ісі
- Бизнесті бағалау
- Биология
- Бухгалтерлік іс
- Валеология
- Ветеринария
- География
- Геология, Геофизика, Геодезия
- Дін
- Ет, сүт, шарап өнімдері
- Жалпы тарих
- Жер кадастрі, Жылжымайтын мүлік
- Журналистика
- Информатика
- Кеден ісі
- Маркетинг
- Математика, Геометрия
- Медицина
- Мемлекеттік басқару
- Менеджмент
- Мұнай, Газ
- Мұрағат ісі
- Мәдениеттану
- ОБЖ (Основы безопасности жизнедеятельности)
- Педагогика
- Полиграфия
- Психология
- Салық
- Саясаттану
- Сақтандыру
- Сертификаттау, стандарттау
- Социология, Демография
- Спорт
- Статистика
- Тілтану, Филология
- Тарихи тұлғалар
- Тау-кен ісі
- Транспорт
- Туризм
- Физика
- Философия
- Халықаралық қатынастар
- Химия
- Экология, Қоршаған ортаны қорғау
- Экономика
- Экономикалық география
- Электротехника
- Қазақстан тарихы
- Қаржы
- Құрылыс
- Құқық, Криминалистика
- Әдебиет
- Өнер, музыка
- Өнеркәсіп, Өндіріс
Қазақ тілінде жазылған рефераттар, курстық жұмыстар, дипломдық жұмыстар бойынша біздің қор #1 болып табылады.



Ақпарат
Қосымша
Email: info@stud.kz